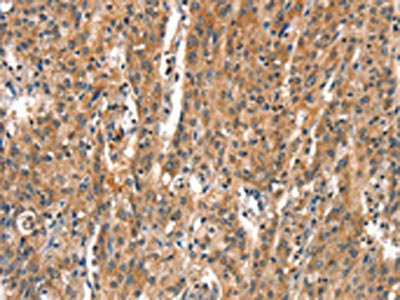

DEAF1 Antibody
-
中文名稱:DEAF1兔多克隆抗體
-
貨號:CSB-PA234417
-
規格:¥1100
-
圖片:
-
The image on the left is immunohistochemistry of paraffin-embedded Human gastic cancer tissue using CSB-PA234417(DEAF1 Antibody) at dilution 1/15, on the right is treated with synthetic peptide. (Original magnification: ×200)
-
The image on the left is immunohistochemistry of paraffin-embedded Human thyroid cancer tissue using CSB-PA234417(DEAF1 Antibody) at dilution 1/15, on the right is treated with synthetic peptide. (Original magnification: ×200)
-
-
其他:
產品詳情
-
Uniprot No.:
-
基因名:DEAF1
-
別名:Deaf1 antibody; DEAF1 transcription factor antibody; DEAF1_HUMAN antibody; Deformed epidermal autoregulatory factor 1 homolog antibody; Nuclear DEA1 related transcriptional regulator antibody; Nuclear DEAF-1-related transcriptional regulator antibody; NUDR antibody; SPN antibody; Suppressin antibody; Zinc finger MYND domain containing protein 5 antibody; Zinc finger MYND domain-containing protein 5 antibody; ZMYND5 antibody
-
宿主:Rabbit
-
反應種屬:Human
-
免疫原:Synthetic peptide of Human DEAF1
-
免疫原種屬:Homo sapiens (Human)
-
標記方式:Non-conjugated
-
抗體亞型:IgG
-
純化方式:Antigen affinity purification
-
濃度:It differs from different batches. Please contact us to confirm it.
-
保存緩沖液:-20°C, pH7.4 PBS, 0.05% NaN3, 40% Glycerol
-
產品提供形式:Liquid
-
應用范圍:ELISA,IHC
-
推薦稀釋比:
Application Recommended Dilution ELISA 1:1000-1:2000 IHC 1:25-1:100 -
Protocols:
-
儲存條件:Upon receipt, store at -20°C or -80°C. Avoid repeated freeze.
-
貨期:Basically, we can dispatch the products out in 1-3 working days after receiving your orders. Delivery time maybe differs from different purchasing way or location, please kindly consult your local distributors for specific delivery time.
-
用途:For Research Use Only. Not for use in diagnostic or therapeutic procedures.
相關產品
靶點詳情
-
功能:Transcription factor that binds to sequence with multiple copies of 5'-TTC[CG]G-3' present in its own promoter and that of the HNRPA2B1 gene. Down-regulates transcription of these genes. Binds to the retinoic acid response element (RARE) 5'-AGGGTTCACCGAAAGTTCA-3'. Activates the proenkephalin gene independently of promoter binding, probably through protein-protein interaction. When secreted, behaves as an inhibitor of cell proliferation, by arresting cells in the G0 or G1 phase. Required for neural tube closure and skeletal patterning. Regulates epithelial cell proliferation and side-branching in the mammary gland. Controls the expression of peripheral tissue antigens in pancreatic lymph nodes. Isoform 1 displays greater transcriptional activity than isoform 4. Isoform 4 may inhibit transcriptional activity of isoform 1 by interacting with isoform 1 and retaining it in the cytoplasm. Transcriptional activator of EIF4G3.
-
基因功能參考文獻:
- The results demonstrate that variants located within the neurodevelopmental disorder (DAND)or NLS domains significantly reduce DEAF1 transcriptional regulatory activities and are thus, likely to contribute to the underlying clinical concerns in DAND patients. PMID: 28940898
- identified pathogenic de novo variants in two cases, a nonsense variant in IQSEC2 and a missense variant in the SAND domain of DEAF1 PMID: 28213671
- We conclude that this DEAF1 gene alteration caused this patient's symptoms and that white matter disease should not be considered a obligate feature of this syndrome. PMID: 26834045
- RAI1 polymorphisms rs4925102 and rs9907986 are predicted to disrupt the binding of retinoic acid RXR-RAR receptors and the transcription factor DEAF1, respectively, in Smith-Magenis and Potocki-Lupski syndromes patients. PMID: 26743651
- an autosomal recessive splice acceptor mutation in DEAF1 (c.997+4A>C, p.G292Pfs*) in all affected individuals, which led to exon skipping, and reduced the normal full-length mRNA copy number in the patients with epilepsy and extrapyramidal symptoms PMID: 26048982
- Data show that deformed epidermal autoregulatory factor-1 (DEAF1) was located in the nucleus under the fluorescence microscope. PMID: 26271982
- These data suggest that during the progression of type 1 diabetes, inflammation and hyperglycemia mediate the splicing of DEAF1 and loss of peripheral tissue antigen expression. PMID: 25187368
- This study indicates, for the first time, a hereditary role of DEAF1 in white matter abnormalities, microcephaly and syndromic intellectual disability. PMID: 24668509
- these results demonstrate that mutations in DEAF1 cause ID and behavioral problems, most likely as a result of impaired transcriptional regulation by DEAF1. PMID: 24726472
- Pellino1 interacts with the transcription factor Deformed Epidermal Autoregulatory Factor 1 (DEAF1). PMID: 23846693
- Non-genomic downregulation of 5-HT1A receptor by 17beta-estradiol does not involve NUDR and Freud-1 proteins. PMID: 22328058
- DEAF1 can interact with the DNA-PK complex through interactions of its DNA binding domain with the carboxy-terminal region of Ku70 that contains the Bax binding domain, and that DEAF1 is a potential substrate for DNA-PK. PMID: 22442688
- Data identify DEAF1 as an interactor and in vitro substrate of GSK3A and GSK3B that interacts with the phosphatidylinositol 3-kinase-mammalian target of rapamycin pathway. PMID: 20368287
- These results suggest that transcription factors such as Aire and Deaf1, which exert global transcriptional regulatory functions, may play important roles in self-renewal of ESCs and maintaining ESC in a transcriptionally hyperactive state. PMID: 20226168
- The spn gene was mutated in the primary CRC, the expression of SPN was primarily cytoplasmic in nonmucinous CRCs and nuclear in mucinous CRCs. PMID: 11705868
- DEAF1 has nuclear export signal and protein interaction domains PMID: 15161925
- Cell-specific regulation by Deaf-1 could underlie region-specific alterations in 5-HT1A receptor expression in different mood disorders. PMID: 16467535
- In this study the NUDR immunoreactivity as measured by Western blot was significantly decreased in the prefrontal cortex of female depressed subjects (42%, p=0.02) and unchanged in male depressed subjects relative to gender-matched control subjects. PMID: 18561871
- Overexpression of transgenic DEAF-1 in human breast epithelial cells enhances cell proliferation. PMID: 18826651
- DEAF-1 is a trans-acting factor that merits further investigation as a potential tool for modulating GDF5 expression. PMID: 19565498
- Lower peripheral tissue antigens (PTA) expression resulting from the alternative splicing of DEAF1 may contribute to the pathogenesis of type 1 diabetes. PMID: 19668219
顯示更多
收起更多
-
相關疾病:Mental retardation, autosomal dominant 24 (MRD24); Dyskinesia, seizures, and intellectual developmental disorder (DYSEIDD)
-
亞細胞定位:[Isoform 1]: Nucleus. Cytoplasm. Note=Cytoplasmic in non-mucinous colorectal carcinoma. When expressed alone, localized almost exclusively in the nucleus but, when expressed with isoform 4, nuclear expression decreases to 32% and cytoplasmic expression increases by 270%.; [Isoform 2]: Secreted. Note=Secreted in some cell types.; [Isoform 3]: Secreted. Note=Secreted in some cell types.; [Isoform 4]: Cytoplasm. Nucleus. Note=When expressed alone, localizes mainly in the cytoplasm but, when expressed with isoform 1, nuclear localization is enhanced.
-
組織特異性:Expressed in various tissues and cells such as in peripheral mononuclear cells and hormone-secreting pituitary cells. Expression in pancreatic lymph nodes of patients with type 1 diabetes is 20 times higher than in healthy controls. Highly expressed in fe
-
數據庫鏈接:
Most popular with customers
-
-
YWHAB Recombinant Monoclonal Antibody
Applications: ELISA, WB, IHC, IF, FC
Species Reactivity: Human, Mouse, Rat
-
Phospho-YAP1 (S127) Recombinant Monoclonal Antibody
Applications: ELISA, WB, IHC
Species Reactivity: Human
-
-
-
-
-